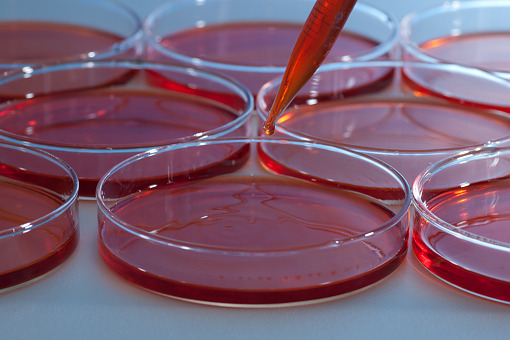

10.07.2023
Redaktor:
Aleksandra Lang
Liszaj amyloidowy
Liszaj amyloidowy jest rzadką chorobą o charakterystycznym obrazie klinicznym, dermoskopowym i histopatologicznym. Chociaż jest to forma pierwotnej amyloidozy skóry, może współistnieć z chorobami autoimmunologicznymi, alergicznymi lub endokrynologicznymi. Metody leczenia oparte są na opisach przypadków, brakuje wytycznych dotyczących preferowanego leczenia.
WPROWADZENIE
Liszaj amyloidowy jest najczęstszą postacią pierwotnej zlokalizowanej (postać grudkowa). Innymi, rzadziej opisywanymi odmianami są amyloidoza plamista i guzkowa. Niekiedy różne postacie mogą współwystępować. Na typowy obraz kliniczny liszaja amyloidowego składają się skupiska hiperpigmentacyjnych grudek, które umiejscawiają się zazwyczaj na powierzchniach wyprostnych kończyn dolnych. W obrazie histologicznym stwierdza się obecność materiału amyloidowego w warstwie brodawkowatej skóry właściwej, co znajduje potwierdzenie w badaniach z zastosowaniem immunofluorescencji bezpośredniej i metod immunohistochemicznych. Nie ma obecnie wytycznych dotyczących metod leczenia.
OPIS PRZYPADKU
Kobieta 63-letnia zgłosiła się do poradni dermatologicznej z powodu hiperkeratotycznych, przebarwionych grudek umiejscowionych na powierzchniach wyprostnych kończyn dolnych. Zmianom towarzyszył świąd. Zmiany utrzymywały się od około 10 lat. W wywiadzie chorobowym stwierdzono cukrzycę typu 2, nadciśnienie, zapalenie dróg żółciowych, kamicę przewodu żółciowego wspólnego, stan po endoskopowej cholangiopankreatografii wstecznej z wszczepieniem stentu oraz marskość wątroby.
W obrazie dermoskopowym uwidoczniono białą, centralnie umiejscowioną zmianę ogniskową otoczoną brązowo-szarawymi kropkami i nadżerkami). W wycinku skóry pobranym do badania stwierdzono amorficzne, eozynofilowe złogi w warstwie brodawkowatej skóry właściwej, podnaskórkowe pęcherzyki oraz w naskórku cechy przewlekłego drażnienia mechanicznego.
Obraz kliniczny, dermoskopowy i histopatologiczny wskazywały jednoznacznie na rozpoznanie liszaja amyloidowego. W leczeniu pacjentki zastosowano 0,05% propionian klobetazolu w maści z okluzją oraz kwas salicylowy z 10-procentowym mocznikiem. Uzyskano znaczną poprawę stanu klinicznego i ustąpienie świądu.
Pełen tekst artykułu: <b>Liszaj amyloidowy
Liszaj amyloidowy jest najczęstszą postacią pierwotnej zlokalizowanej (postać grudkowa). Innymi, rzadziej opisywanymi odmianami są amyloidoza plamista i guzkowa. Niekiedy różne postacie mogą współwystępować. Na typowy obraz kliniczny liszaja amyloidowego składają się skupiska hiperpigmentacyjnych grudek, które umiejscawiają się zazwyczaj na powierzchniach wyprostnych kończyn dolnych. W obrazie histologicznym stwierdza się obecność materiału amyloidowego w warstwie brodawkowatej skóry właściwej, co znajduje potwierdzenie w badaniach z zastosowaniem immunofluorescencji bezpośredniej i metod immunohistochemicznych. Nie ma obecnie wytycznych dotyczących metod leczenia.
OPIS PRZYPADKU
Kobieta 63-letnia zgłosiła się do poradni dermatologicznej z powodu hiperkeratotycznych, przebarwionych grudek umiejscowionych na powierzchniach wyprostnych kończyn dolnych. Zmianom towarzyszył świąd. Zmiany utrzymywały się od około 10 lat. W wywiadzie chorobowym stwierdzono cukrzycę typu 2, nadciśnienie, zapalenie dróg żółciowych, kamicę przewodu żółciowego wspólnego, stan po endoskopowej cholangiopankreatografii wstecznej z wszczepieniem stentu oraz marskość wątroby.
W obrazie dermoskopowym uwidoczniono białą, centralnie umiejscowioną zmianę ogniskową otoczoną brązowo-szarawymi kropkami i nadżerkami). W wycinku skóry pobranym do badania stwierdzono amorficzne, eozynofilowe złogi w warstwie brodawkowatej skóry właściwej, podnaskórkowe pęcherzyki oraz w naskórku cechy przewlekłego drażnienia mechanicznego.
Obraz kliniczny, dermoskopowy i histopatologiczny wskazywały jednoznacznie na rozpoznanie liszaja amyloidowego. W leczeniu pacjentki zastosowano 0,05% propionian klobetazolu w maści z okluzją oraz kwas salicylowy z 10-procentowym mocznikiem. Uzyskano znaczną poprawę stanu klinicznego i ustąpienie świądu.
Pełen tekst artykułu: <b>Liszaj amyloidowy




